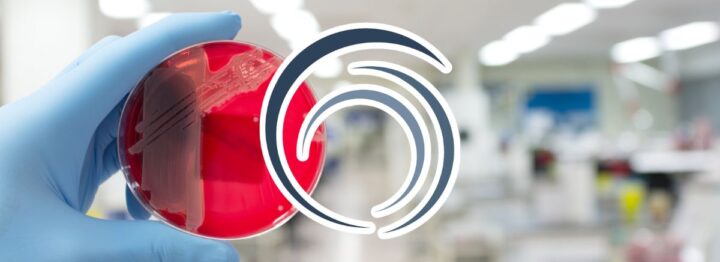

Ultimo Aggiornamento 29 Settembre 2025
Per “infezioni nosocomiali”, o ospedaliere, che in realtà dovremmo chiamare Infezioni Correlate all’Assistenza (ICA), intendiamo quelle infezioni contratte in ambito sanitario, soprattutto ospedaliero, non presenti al momento del primo ingresso del paziente e che insorgono ameno 48 ore dopo il ricovero ed entro i tre giorni dalla dimissione.
Causate dalla presenza di microrganismi patogeni opportunisti in ambiente ospedaliero, le infezioni ospedaliere – nell’acronimo inglese H.C.A.I.: Health Care Acquired Infections – sono, per definizione, quelle infezioni che non erano presenti (quindi non erano manifeste clinicamente, né erano in incubazione) all’ingresso del paziente nell’ambiente di ricovero o di assistenza, ed insorgono durante il ricovero e la degenza o, più raramente, dopo le dimissioni del paziente.
Secondo i C.D.C. di Atlanta (Centers for Disease Control and Prevention), sono da considerare infezioni correlate all’assistenza quelle i cui sintomi e segni sono insorti a partire dal terzo giorno di ricovero in poi (dovendosi reputare “esterne” quelle presenti fin dall’ingresso in ospedale, cioè a dire insorte da due giorni prima del ricovero e fino ai primi due giorni di ricovero).
INDICE SOMMARIO
- § 1. Cosa s’intende per infezioni nosocomiali
- § 2. Siti di sviluppo delle infezioni ospedaliere
- § 3. Cause delle Infezioni Correlate all’Assistenza
- § 4. Come prevenire le Infezioni Correlate all’Assistenza
- § 5. Prevedibilità ed evitabilità delle infezioni nosocomiali
- § 6. Le regole processuali in materia di risarcimento del danno da ICA
- § 7. Alcuni nostri casi di Infezioni Correlate all’Assistenza sanitaria
- § 8. Risorse e approfondimenti
§ 1. Cosa s’intende per infezioni nosocomiali
Le infezioni nosocomiali, anche dette infezioni correlate all’assistenza sanitaria, sono infezioni contratte in ambito sanitario, in particolare ospedaliero, che non erano presenti né in incubazione al momento del primo ingresso del paziente. Queste infezioni si manifestano generalmente almeno 48 ore dopo il ricovero e possono insorgere fino a tre giorni dopo la dimissione.
Si tratta di infezioni strettamente legate al contesto ospedaliero e alla permanenza in ambienti sanitari, dove possono essere favorite da fattori come la presenza di dispositivi medici, procedure invasive o la vulnerabilità dei pazienti già debilitati.
§ 1.1 Da infezioni nosocomiali a ICA
Al fine di superare l’originaria definizione di “infezioni nosocomiali” legata a tutte quelle infezioni contraibili nel solo ambito ospedaliero, il Ministero della Salute ha proceduto ad una loro classificazione in termini di
“infezioni acquisite che costituiscono la complicanza più frequente e grave dell’assistenza sanitaria e possono verificarsi in ogni ambito assistenziale, inclusi gli ospedali per acuti, il day-hospital/day-surgery, le strutture di lungodegenza, gli ambulatori, l’assistenza domiciliare, le strutture residenziali territoriali”[*].
[*] “Infezioni correlate all’assistenza: cosa sono e cosa fare”, Ministero della Salute, 2022
Rileva quindi il fatto che le Infezioni Correlate all’Assistenza non sono solo tipiche dell’ambiente ospedaliero in senso stretto, ma possono verificarsi in qualunque setting assistenziale: ospedali, ambulatori territoriali, RSA e persino l’assistenza domiciliare.
Proprio per questa ragione, le ICA comprendono anche le infezioni contratte non solo dal paziente, ma anche dagli operatori sanitari a contatto coi pazienti, anche se questa seconda eventualità insorge in misura minore.
Dunque, riassumendo, le ICA si qualificano come:
- infezioni che conseguono ad interventi/procedimenti sanitari;
- infezioni contratte in ambiente sanitario (ricoveri, ambiti socio-sanitari, etc.);
- infezioni che interessano sia i pazienti sia – in misura minore – il personale sanitario o socio sanitario che presta assistenza.
§ 1.2 Tipologie di ICA
Relativamente alla provenienza dell’agente eziologico, le infezioni ospedaliere si suddividono in:
- infezioni endogene: che originano dalla flora microbica che colonizza il paziente (anche definite, più in generale, “autogene”);
- infezioni esogene: acquisite dall’ambiente o da altri ricoverati che presentano infezioni, per lo più di origine comunitaria;
- infezioni latenti: sostenute prevalentemente da virus erpetici, micobatteri, miceti o protozoi, in special modo tra i pazienti sottoposti a trapianto di organi o di midollo osseo.
I più frequenti veicoli di trasmissione delle infezioni nosocomiali sono:
- le mani degli operatori sanitari;
- i cd. oggetti critici, per i quali è previsto un contatto con tessuti e distretti abitualmente sterili del corpo umano o con superfici mucose lesionate (ad es. aghi, lame di bistruri, ablatori, frese);
- i cd. oggetti semicritici, che vengono in contatto con mucose integre (endoscopi, broncoscopi, manipoli, portaimpronte odontoiatrici);
- i cd. oggetti non critici, che vengono in contatto soltanto con la cute indenne (fonendoscopio, sfigmomanometro, barella, padella, poltrona del riunito odontoiatrico);
- i cd. oggetti a rischio trascurabile, per cui non è previsto un contatto con i degenti e/o con gli operatori (pareti, pavimenti, superfici, ecc.);
- i sistemi di ventilazione od aerazione;
- la rete idrica e i flussi d’acqua.
§ 2. Siti di sviluppo delle infezioni ospedaliere
Approssimativamente l’80% di tutte le infezioni nosocomiali riguarda quattro siti principali:
- il tratto urinario,
- le ferite chirurgiche,
- l’apparato respiratorio,
- le infezioni sistemiche (sepsi, batteriemie).
Quelle statisticamente più diffuse sono le infezioni del tratto urinario: da da sole rappresentano il 35-40% di tutte le infezioni acquisite in ospedale.
Le cinque principali infezioni correlate all’assistenza sanitaria in ospedale comprendono (la percentuale indicata fra parentesi indica l’incidenza sul totale dei costi che le infezioni comportano):
- le infezioni del sito chirurgico (33,7%), che colpiscono mediamente da 2 a 5 pazienti su 100 operati, prolungando mediamente la durata del ricovero di 10-14 giorni ed aumentando il rischio di morte da 2 a 11 volte;
- le polmoniti acquisite in ospedale – H.A.P., Hospital Acquired Pneumonia, o H.C.A.P., Health Care Associated Pneumonia – e, in particolare, quelle associate a ventilazione meccanica – V.A.P.: Ventilator Acquired Pneumonia – (31,6%);
- le setticemie correlate a catetere vascolare centrale (18,9%), che interessano con elevata frequenza i pazienti ricoverati in reparti di terapia intensiva e sono favorite anche dalle condizioni cliniche del degente, atte ad amplificare suscettibilità e gravità delle infezioni ematiche associate al dispositivo CVC;
- le infezioni da Clostridium Difficile (15,4%), tipicamente rappresentate da coliti che portano con sé un aumento della morbidità e della mortalità, specialmente in pazienti clinicamente fragili come anziani, affetti da multiple comorbosità croniche e ricoverati spesso per altre patologie acute;
- le infezioni del catetere urinario (<1%), la maggior parte delle quali è associata alla presenza di catetere uretero-vescicale a permanenza.
§ 3. Cause delle Infezioni Correlate all’Assistenza
Cause delle Infezioni Correlate all’Assistenza
Le cause delle ICA sono direttamente correlate alle fonti di infezione.
Per fare in modo che un’infezione insorga, devono essere presenti tre condizioni:
- l’agente patogeno,
- la fonte d’infezione,
- l’ospite
§ 3.1 Agente patogeno
Affinché un’Infezione Correlata all’Assistenza si verifichi, deve esserci un batterio o virus a causarla.
Tra i batteri più comuni nelle ICA si annoverano non soltanto i c.d. “gram negativi” (Escherichia Coli e Klebsiella Pneumoniae, Acintobacter Baumannii, Pseudomonas Aeruginosa, Salmonella Spp.), ma, correlati allo scorretto utilizzo di dispositivi medici nonché – più in generale – di strumenti in materiale plastico, anche agenti gram positivi (quali Clostridium Difficile, Stafilococcus Epidermidis, Aspergillo, Enterococchi e, non da ultimo, i miceti tra cui spicca la Candida).
Tra gli agenti patogeni tradizionali capaci di indurre ICA si annoverano anche alcuni virus, tra cui quelli dell’epatite e l’influenzale.
§ 3.2 Fonte d’infezione
Affinché l’agente patogeno arrivi a infettare un organismo è, prima di tutto, necessaria la presenza di una fonte infettiva, cioè un iniziale punto di contaminazione.
Le fonti principali sono:
- i sistemi di ventilazione od aerazione;
- i flussi d’acqua;
- il contatto con animali;
- il trattamento di tessuti e campioni di laboratorio;
- l’igiene del personale e dell’ambiente;
- le pratiche chirurgiche e gli ausili invasivi;
- l’uso errato di antibiotici (che può determinare l’insorgere di resistenze).
§ 3.3 Ospite
L’Infezione Nosocomiale per insorgere deve attecchire in un ospite, un organismo che viene a contatto con l’agente patogeno e che sviluppa l’infezione.
Le cause dell’insorgenza possono essere:
- intrinseche: età, status patologico, malnutrizione, alterazioni dello stato di coscienza, compresenza di uno stato immunitario deficitario o di comorbidità;
- estrinseche: traumi, ustioni, trapianti d’organo e, in generale, le procedure invasive o assistenziali a cui è sottoposto l’ospite in ambito sanitario, o altre fonti di contaminazioni come quelle già accennate.
Oltre a queste fonti principali di infezione, il rischio di contrarre un’ICA può essere correlato anche alla lunghezza del ricovero: secondo un’indagine OMS, le infezioni nosocomiali possono aumentare in degenze superiori ai sette giorni.
§ 4. Come prevenire le Infezioni Correlate all’Assistenza
Con specifico riferimento alle infezioni del sito chirurgico (che rappresentano la seconda infezione ospedaliera per frequenza in Europa e sono spesso la complicanza infettiva più insidiosa e dispendiosa), si stima che:
- almeno il 60% dei casi potrebbe essere prevenuto con una stretta adesione alle indicazioni delle linee guida di prevenzione;
- il paziente che ne risulta colpito ha un rischio maggiore di morte (da 2 a 11 volte);
- oltre il 70% di questi decessi sono direttamente attribuibili alla S.S.I. (Surgical Site Infection).
Giova poi ricordare le più recenti revisioni critiche delle misure preventive delle infezioni correlate all’assistenza, che evidenziano il ruolo centrale della sterilità degli operatori e delle strumentazioni durante l’assistenza al malato. Secondo tale impostazione, il messaggio più importante è quello di cominciare a pensare alle infezioni non solo come evento legato alla ospedalizzazione, ma come l’effetto diretto di una scorretta o scadente qualità nelle procedure medico-sanitarie. In questo senso, l’infezione non è legata al luogo, ma alla procedura; non è più solo “dell’ospedale”, ma di ogni Operatore Sanitario, sia esso ospedaliero o di altre strutture sanitarie territoriali.
§ 4.1 L’igiene delle mani
Tutti gli studi epidemiologici condotti in tema di infezioni nosocomiali hanno evidenziato che la modalità più frequente con cui si trasmette un microrganismo ad un ricoverato è per contatto diretto, in primis attraverso le mani del personale di assistenza e, più di rado, con il vestiario, lo strumentario medico, ecc.
Su questo tema si rimanda, altresì, al volume di Thierry Crouzet, Clean hands save lives, (Parigi, 2014) che ha dato vita all’omonimo progetto, senza dimenticare che anche l’Organizzazione Mondiale della Sanità ha dedicato una giornata (il 5 maggio di ogni anno) all’igiene delle mani, per sottolineare l’estrema importanza di questa pratica assistenziale al fine di proteggere i pazienti dalla trasmissione di Infezioni Correlate all’Assistenza.
§ 5. Prevedibilità ed evitabilità delle infezioni nosocomiali
Sul profilo della evitabilità o inevitabilità delle infezioni nosocomiali, il criterio guida deve essere rappresentato dalle regole giuridiche vigenti in materia di responsabilità medico-sanitaria, che – come noto – ha natura contrattuale:
“Ai fini del riparto dell’onere probatorio, l’attore, paziente danneggiato, deve limitarsi a provare l’esistenza del contratto (o del contatto sociale) e l’insorgenza o l’aggravamento della patologia ed allegare l’inadempimento del debitore, astrattamente idoneo a provocare il danno lamentato, rimanendo a carico del debitore dimostrare o che tale inadempimento non vi è stato ovvero che, pur esistendo, esso non è stato eziologicamente rilevante”
(ex pluribus, Cass. III, 11/03/2016, n. 4764).
In sostanza, è ragionevole ritenere sia sussistente la responsabilità dell’Ente Ospedaliero nella genesi dell’infezione correlata all’assistenza, salvo che lo stesso non riesca a dimostrare che la propria Struttura e il proprio personale agirono nel pieno rispetto di diligenza e prudenza qualificata e proporzionata alla natura della prestazione, e che venne fatto tutto il possibile per evitare il contagio in base alle indicazioni ampiamente condivise e pretese dalla letteratura scientifica, nonché dalle vigenti previsioni normative.
In linea generale, con riguardo alla tematica delle infezioni ospedaliere, giova segnalare che esse rappresentano un fenomeno sicuramente prevedibile poiché trattasi di una delle più comuni “complicanze” di ogni intervento chirurgico.
Inoltre, la letteratura, tanto nazionale quanto internazionale è univoca nell’indicare come le infezioni correlate all’assistenza, e in particolare quelle del sito chirurgico, siano assolutamente evitabili.
Si confrontino, in proposito, le seguenti indicazioni della dottrina scientifica (riferite – specificamente – al fenomeno delle infezioni del sito chirurgico):
“Viene stimato che il 60% circa dei casi potrebbe essere prevenuto con una adesione alle indicazioni delle linee guida di prevenzione, che il paziente che ne risulta colpito ha un rischio maggiore di morte da 2 a 11 volte, che oltre il 70% di questi decessi sono direttamente attribuibili alla SSI” [Surgical Site Infection];
P. COSTIGLIOLA, Le infezioni correlate all’assistenza e principi di prevenzione, in F.M. DONELLI e M. GABBRIELLI (a cura di), La responsabilità medica nelle infezioni ospedaliere, Maggioli, 2014, p. 27.
Nello stesso senso: M.S. VERZURI e M. BIANCHI, Le Linee Guida, in F.M. DONELLI e M. GABBRIELLI [a cura di], La responsabilità medica nelle infezioni ospedaliere, cit., p. 132.
Per la letteratura internazionale (in tema di Surgical Site Infections), si veda:
“Up to 60% of SSIs have been estimated to be preventable by using evidence-based guidelines”
D.J. ANDERSON, Strategies to Prevent Surgical Site Infections in Acute Care Hospitals: 2014 Update, in Infect. Control Hosp. Epidemiol., 2014, Jun, pp. 605–627.
E’ pertanto evidente come si renda mandatoria la massima attenzione preventiva da parte di ogni struttura sanitaria, mediante adozione di idonee misure atte a garantire la sterilità degli ambienti, del personale e delle attrezzature, che debbono essere sottoposte a costante e continuo monitoraggio.
§ 6. Le regole processuali in materia di risarcimento del danno da ICA
Contrarre un’Infezione Correlata all’Assistenza sanitaria può provocare seri danni alla persona quando non gravissimi o, addirittura, letali.
Le procedure giudiziali risarcitorie in materia di danni derivanti da I.C.A. sono assai complesse ed articolate, e può non essere agevole districarsi nei meandri della responsabilità – talvolta contrattuale, talatra aquiliana – che compete alla struttura sanitaria in cui si è verificato il contagio infettivo, con riferimento ai profili della colpa, del danno e del nesso causale, oltre che dell’onere della prova di ciascuno di tali presupposti.
Vengono però in soccorso, in ottica ricostruttiva e riepilogativa, tre recenti pronunce della Suprema Corte:
- la prima è una ordinanza (Cass. III, 22/02/2023, n. 5490) e riguarda un caso di responsabilità – esplicitamente riconosciuta come contrattuale – per il decesso di una paziente diabetica verificatosi a causa di una infezione da Stafilococco Aureo (verosimilmente MRSA), contratta in occasione di un non meglio precisato intervento chirurgico;
- la seconda è anch’essa una ordinanza (Cass. III, 27/02/2023, n. 5808) e concerne un caso di responsabilità – pacificamente contrattuale – per una infezione conseguita ad intervento chirurgico in zona coxo-femorale;
- la terza è invece una sentenza (Cass. III, 03/03/2023, n. 6386) e attiene a un’ipotesi di responsabilità – stavolta dichiaratamente qualificata come extracontrattuale – per la morte di una anziana paziente determinata da infezione dall’ubiquo MRSA (Stafilococco Aureo Meticillino-Resistente), sopravvenuta all’esito di una caduta in ospedale.
Vedremo, tuttavia, che le regole del gioco sono sostanzialmente le stesse, ad onta della diversità del titolo di responsabilità (e dell’ondivago criterio con cui si sceglie di determinarlo).
§ 6.1 I.C.A. e responsabilità contrattuale: il dictum di Cass. n. 5490/2023
Il caso, come accennato, aveva visto decedere una donna, non priva di comorbilità, per le conseguenze di una infezione da MRSA contratta in ambito chirurgico. Ad agire per il risarcimento danni (sia iure hereditatis sia iure proprio) erano i figli suprestiti della paziente. In primo grado il Tribunale di Verbania aveva rigettato la domanda; la Corte d’Appello di Torino aveva confermato la pronuncia, addirittura dichiarando inammissibile l’appello. La Suprema Corte ha, invece, accolto l’impugnazione dei ricorrenti e cassato la sentenza.
Molto interessanti sono le osservazioni che, in ottica ricostruttiva e preliminare, la Cassazione dedica alla natura della responsabilità della casa di cura che – afferma testualmente la pronuncia – “ha natura contrattuale e può derivare […] tanto dall’inadempimento della prestazione medico-professionale svolta direttamente dal sanitario (quale suo ausiliario necessario, pur in assenza di un rapporto di lavoro subordinato), quanto dall’inadempimento delle specifiche prestazioni proprie della casa di cura“, tra le quali riveste particolare importanza il tema della “sicurezza delle cure“, che postula il “riconoscimento del valore fondamentale e indefettibile della rigorosa adozione, da parte dei responsabili della struttura sanitaria, di ogni possibile iniziativa volta a salvaguardare l’incolumità dei pazienti ospitati presso i locali della struttura […]” (così, letteralmente, Cass. III, 22/02/2023, n. 5490).
Trattasi, come è noto e come ricorda la stessa Cassazione, di un principio cogente, già richiamato da fonti normative di rango sovranazionale e ribadito dalla norma di apertura della legge Gelli, a mente della quale “La sicurezza delle cure si realizza anche mediante l’insieme di tutte le attività finalizzate alla prevenzione e alla gestione del rischio connesso all’erogazione di prestazioni sanitarie […]“, nel quadro di quelle “attività di prevenzione del rischio“, cui “è tenuto a concorrere tutto il personale, compresi i liberi professionisti che vi operano in regime di convenzione con il Servizio sanitario nazionale” (così l’art. 1 della legge n. 24/2017).
Ne deriva, come anche noi abbiamo più volte sottolineato, che il cd. risk management è oggi entrato nel contenuto dell’obbligazione che la struttura sanitaria deve rispettare per assolvere il proprio dovere di cura: non gestire o gestire malamente il rischio clinico costituisce una violazione di questo dovere, e questa violazione comporta responsabilità.
Bene, fatta questa doverosa quanto icastica premessa, la Suprema Corte prosegue nell’analisi della vicenda clinica e – muovendo sempre dalla natura contrattuale della responsabilità – ribadisce questi lineari principi:
- è onere del danneggiato provare, anche a mezzo di presunzioni, il nesso causale fra la condotta sanitaria e il danno evento (aggravamento della situazione patologica o insorgenza di nuove patologie);
- quando il danneggiato ha provato il nesso di causa, diventa onere del danneggiante provare che l’inesatto adempimento della prestazione fosse dovuto ad una causa imprevedibile e inevitabile;
Dunque, applicando specificamente queste regole in campo I.C.A.:
- accertata la diretta riconducibilità causale dell’infezione ospedaliera all’intervento chirurgico, i danneggiati hanno assolto l’onere di comprovare il nesso eziologico;
- a quel punto, dunque, incombeva sulla struttura sanitaria convenuta, al fine di esimersi da ogni responsabilità per il decesso della paziente, l’onere di fornire la prova della specifica causa imprevedibile e inevitabile dell’impossibilità di esatta esecuzione della prestazione.
Con la precisazione, per inciso, che la prova liberatoria per la struttura non è soddisfatta dalla mera astratta previsione di misure preventive e/o protocolli potenzialmente idonei a scongiurare il rischio infettivo, bensì dalla dimostrazione dell’effettivo rispetto di tali misure e protocolli nel caso specifico, nonché dell’efficace attuazione, nel caso concreto, di tutti i presidi necessari a proteggere il paziente dal rischio di quella specifica infezione nosocomiale che ne ha determinato la morte.
Res ipsa loquitur, fino a prova contraria. Rinvio alla Corte d’Appello di Torino, dunque, per rivalutare il caso sulla scorta di questi principi.
§ 6.2 Ancora su I.C.A. e responsabilità contrattuale: le precisazioni di Cass. n. 5808/2023
Il caso riguardava un paziente che aveva contratto una Infezione Correlata all’Assistenza in occasione di un intervento chirurgico al collo del femore, che gli aveva infine provocato – pur lasciandolo in vita – una “necrosi cefalica femorale in sede di pregressa frattura basicervicale sinistra”, con necessità di installare protesi d’anca. L’Azienda Sanitaria era stata condannata, sia in primo che in secondo grado (Tribunale e poi Corte d’Appello di Palermo), a risarcirgli il danno non patrimoniale nella misura di euro 152.000.
La Corte di Cassazione, adita dall’Azienda soccombente, ha respinto il ricorso, richiamando innanzitutto il consolidato principio di diritto, già formulato da Cass. n. 26700/2018 (e riaffermato anche successivamente, tra le altre, da Cass. n. 10500/2022), a mente del quale:
“In tema di responsabilità contrattuale della struttura sanitaria, incombe sul paziente che agisce per il risarcimento del danno l’onere di provare il nesso di causalità tra l’aggravamento della patologia (o l’insorgenza di una nuova malattia) e l’azione o l’omissione dei sanitari, mentre, ove il danneggiato abbia assolto a tale onere, spetta alla struttura dimostrare l’impossibilità della prestazione derivante da causa non imputabile, provando che l’inesatto adempimento è stato determinato da un impedimento imprevedibile ed inevitabile con l’ordinaria diligenza. (In applicazione di tale principio, la S.C. ha confermato la sentenza di merito che aveva rigettato la domanda di risarcimento del danno proposta dalla paziente e dai suoi stretti congiunti, in relazione a un ictus cerebrale che aveva colpito la prima a seguito di un esame angiografico, sul rilievo che era mancata la prova, da parte degli attori, della riconducibilità eziologica della patologia insorta alla condotta dei sanitari, ed anzi la CTU espletata aveva evidenziato l’esistenza di diversi fattori, indipendenti dalla suddetta condotta, che avevano verosimilmente favorito l’evento lesivo)“.
(Cass. III, 23/10/2018, n. 26700)
In conformità a tali regole, pertanto, la distribuzione degli oneri tra le parti in materia di Infezioni Correlate all’Assistenza è questa:
- il paziente deve provare il nesso causale tra la degenza ospedaliera ed il contagio infettivo, cioè deve dimostrare che trattasi effettivamente di infezione contratta in ambito nosocomiale (id est: I.C.A.);
- la struttura sanitaria deve provare di aver fatto tutto il possibile per prevenire il contagio, quindi deve fornire la prova liberatoria che l’evenienza infettiva fosse imprevedibile o inevitabile, e come tale non imputabile.
Ancora res ipsa loquitur, dunque: la semplice presenza dell’infezione fa presumere che l’ospedale sia in colpa, a meno che non dimostri di aver adottato tutte le precauzioni necessarie per evitare il contagio e di aver agito con la massima diligenza possibile.
Responsabilità sanitaria e risarcimento confermati, quindi.
§ 6.3 I.C.A. e responsabilità extracontrattuale: i principi espressi da Cass. n. 6386/2023
Qui il caso era quello della morte di una donna, determinata dalle complicanze della solita infezione da Stafilococco Aureo multiresistente, instauratasi in conseguenza di una caduta accidentale della paziente dalla sedia. Rigettate le domande risarcitorie prima dal Tribunale e poi dalla Corte d’Appello di Milano, la Suprema Corte accoglie il ricorso dei parenti e cassa la pronuncia impugnata.
La Cassazione muove dal presupposto – invero contrario a quello della pressoché coeva, sopra citata, Cass. n. 5490/2023 – della natura extracontrattuale dell’azione di responsabilità proposta iure proprio dai parenti del paziente deceduto, perché il contratto (di spedalità), a mente dell’art. 1372 c.c., non esplicherebbe efficacia se non tra le sue parti, e non potrebbe avere, fuori dalle prestazioni sanitarie afferenti la procreazione, effetti protettivi in favore di terzi.
Trattasi, a dire il vero, di questione complessa e controversa, o quantomeno controvertibile, considerato peraltro che c’è una disposizione normativa – l’art. 7, comma 1 della legge Gelli Bianco, appunto – che stabilisce espressamente che “La struttura sanitaria o sociosanitaria pubblica o privata […] risponde, ai sensi degli articoli 1218 e 1228 del codice civile […]“. Non è però questa la sede in cui possiamo approfondire il tema, anche perché abbiamo già sin troppo abusato della pazienza del lettore, perciò dovremo rinviarne ad altra sede la trattazione.
Dunque, proseguendo l’analisi della sentenza, la Suprema Corte assume che i congiunti del paziente deceduto che reclamino di averne sofferto pregiudizio (a proposito: hai già provato il nostro strumento di calcolo del danno da perdita del rapporto parentale in base alle Tabelle di Milano?), possono farlo valere “esclusivamente come illecito aquiliano“, non competendo loro “l’azione di responsabilità contrattuale (spettante unicamente al paziente che ha stipulato il contratto), ma quella di responsabilità extracontrattuale, soggiacendo alla relativa disciplina, anche in tema di onere della prova” (così, Cass. n. 6386/2023).
Sennonché, pur mutando il titolo di responsabilità, i principi applicabili non cambiano.
Se è vero, infatti, che in ambito extracontrattuale il danneggiato deve provare tutti gli elementi costitutivi della responsabilità professionale medica (fatto colposo, danno e nesso causale tra loro), in concreto la Cassazione perviene alla conferma dell’orientamento avallato in materia di responsabilità contrattuale.
Punto di partenza del ragionamento è il richiamo di due precedenti – Cass. III, 23/02/2021, n. 4864, e Cass. III, 15/06/2020, n. 11599 – a conforto della tradizionale ripartizione degli oneri probatori (che, a questo punto, prescinde dal titolo, contrattuale o no, di responsabilità):
- il nesso causale deve provarlo il paziente;
- l’impossibilità incolpevole di adempiere deve provarla la struttura sanitaria.
Da qui la Corte si spinge oltre, ed individua un dettagliato elenco (che invero sembra almeno parzialmente mutuato dalla dottrina medico-legale[*]) delle misure utili alla prevenzione delle l.C.A. .che la struttura sanitaria deve dimostrare di aver messo in campo a fronte della prova della relativa contrazione in ambito ospedaliero.
[*] Cfr. M. Benvenuti, G. Nucci e G. Ceraso, La responsabilità del medico. Dottrina e giurisprudenza, Responsabilità civile, in F.M. Donelli e M. Gabbrielli (a cura di), Responsabilità medica nelle infezioni ospedaliere, spec. p.158.
Vale la pena di trascriverlo letteralmente, questo elenco:
- a) L’indicazione dei protocolli relativi alla disinfezione, disinfestazione e sterilizzazione di ambienti e materiali;
- b) L’indicazione delle modalità di raccolta, lavaggio e disinfezione della biancheria;
- c) L’indicazione delle forme di smaltimento dei rifiuti solidi e dei liquami;
- d) Le caratteristiche della mensa e degli strumenti di distribuzione di cibi e bevande;
- e) Le modalità di preparazione, conservazione ed uso dei disinfettanti;
- f) La qualità dell’aria e degli impianti di condizionamento;
- g) L’attivazione di un sistema di sorveglianza e di notifica;
- h) L’indicazione dei criteri di controllo e di limitazione dell’accesso ai visitatori;
- i) Le procedure di controllo degli infortuni e delle malattie del personale e le profilassi vaccinali;
- j) L’indicazione del rapporto numerico tra personale e degenti;
- k) La sorveglianza basata sui dati microbiologici di laboratorio;
- l) La redazione di un report da parte delle direzioni dei reparti da comunicare alle direzioni sanitarie al fine di monitorare i germi patogeni-sentinella;
- m) L’indicazione dell’orario della effettiva esecuzione delle attività di prevenzione del rischio.
Di nuovo (e, aggiungeremmo, semel pro semper): res ipsa loquitur, e la prova contraria è decisamente ardua da fornire.
Il caso deve perciò tornare alla Corte d’Appello di Milano, in diversa composizione, per una sua diversa valutazione in base alle coordinate ermeneutiche così delineate, al fine di comprendere se la struttura sanitaria abbia effettivamente assolto i gravosi oneri probatori che sulla stessa incombono (a prescindere dal titolo, contrattuale od aquiliano, della sua responsabilità).
§ 7. Alcuni nostri casi di Infezioni Correlate all’Assistenza sanitaria
Qui di seguito troverai una selezione di alcuni dei nostri ultimi casi di Infezione Correlata all’Assistenza risolti con successo:
- Caso di Infezione da Pseudomonas Aeruginosa (euro 930.000,00 di risarcimento);
- Caso di Endocardite infettiva non diagnosticata (euro 815.000,00 di risarcimento);
- Caso di Infezione da Acinetobacter Lwoffii, Micrococcus Species ed Epatite-C (euro 400.000,00 di risarcimento);
- Caso di Morte per I.C.A. (euro 750.000,00 di risarcimento);
- Caso di Infezione della protesi endovascolare (euro 382.000 di risarcimento);
- Caso di Infezione da stafilococco in cardiochirurgia (euro 445.000 di risarcimento).
§ 8. Risorse e approfondimenti
Come abbiamo visto, le infezioni nosocomiali rappresentano una sfida persistente e complessa per il sistema sanitario. Sebbene nel corso degli anni siano stati compiuti progressi significativi e si siano susseguiti interventi normativi e amministrativi, nel nostro Paese manca ancora una strategia realmente efficace e coordinata per contrastare con decisione questo fenomeno.
Nei successivi paragrafi daremo sinteticamente conto, da un lato, dei più recenti orientamenti giurisprudenziali (citati sopra) e, dall’altro, dei più rilevanti provvedimenti normativi e amministrativi, per fornire una visione d’insieme sulle risorse a disposizione e sulle difficoltà ancora da superare.
§ 8.1 La giurisprudenza citata
§ 8.2 Principali provvedimenti (normativi ed amministrativi) sulle infezioni nosocomiali
Purtroppo, nel nostro Paese si è ancora lontani da una efficace strategia di contrasto delle infezioni nosocomiali legate all’assistenza, nonostante i progressi fatti e i ripetuti interventi normativi, tra cui dobbiamo segnalare (in ordine cronologico):
- Circolare Ministero Sanità n. 52/1985 (strategie di contrasto alle infezioni nosocomiali e nascita dei Comitati Infezioni Ospedaliere, CIO);
- Circolare Ministero Sanità n. 8/1988 (lotta contro le infezioni ospedaliere e realizzazione di sistemi di sorveglianza attiva);
- Decreto Ministero della Sanità 13/09/1998 (determinazione degli standards del personale ospedaliero, istituzione Comitati Ospedalieri per le Infezioni Nosocomiali, i quali debbono redigere il cd. “PAICA”, cioè il Piano Annuale delle Infezioni Correlate all’Assistenza);
- D.lgs. 30/12/1992, n. 502 (Riordino della disciplina in materia sanitaria, a norma dell’articolo 1 della legge 23/10/1992, n. 421), come modificato dal D.lgs. 07/12/1993, n. 517;
- D.P.R. 14/01/1997 (Determinazione dei requisiti strutturali, tecnologici ed organizzativi minimi per l’esercizio delle attività sanitarie da parte delle strutture pubbliche e private);
- D.lgs. 24/02/1997, n. 46 (Attuazione della direttiva 93/42/CEE concernente i dispositivi medici);
- Raccomandazioni sul controllo della diffusione nosocomiale dello Staphylococcus aureus resistente alla meticillina (MRSA), 2011;
- Piano Nazionale di Contrasto dell’Antimicrobico-Resistenza (PNCAR) 2017-2020, approvato il 02/11/2017 e prorogato al 2021;
- Linee guida globali per la prevenzione delle infezioni del sito chirurgico, 2017;
- Piano Nazionale della Prevenzione 2020-2025, adottato il 06/08/2020;
- Manuale di implementazione per prevenire e controllare la diffusione di organismi resistenti ai carbapenemi a livello nazionale e nelle strutture sanitarie, 12/11/2020;
- Linee Guida per la prevenzione e il controllo di Enterobatteri, Acinetobacter baumannii e Pseudomonas aeruginosa resistenti ai carbapenemi nelle strutture sanitarie, 22/12/2020.